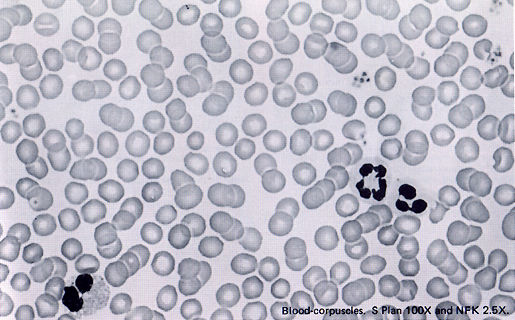

|
Motor Drive 2 If required to release the shutter very quickly in a short time, or control the shutter away from the camera, or take time-lapse photomicrographs of cell division, etc., this Motor Drive 2 is recommended as a high performance motor drive unit capable of consecutive film advance up to 5 frames per second or single frame operation. |
 |
Winder 2 A high speed automatic film winder, weighing only 200g, permits consecutive operation up to 2.5 frames per second as well as single frame operation (film winds in approx. 0.3 sec. and ready for next exposure). |
 |
Recordata Back 4 Interchanges with the standard camera back of the OM-1 N , 2 N, 3, 4 bodies. A compact automatic date and time printing unit that provides a digital printout of either the year, month and day, or the day, hour and minute via pushbutton selector (OFF setting also provided). Data display on the liquid crystal panel. |
Once the date is correctly set, it
keeps the time up to the year 2009, automatically correcting for leap years as well
as the number of days in month. Recordata
Back Section
 |
Recordata Back 2 Interchanges with the standard camera back of the OM-1(1N) and OM-2(2N) prints the year, month and day, code number and other data at the bottom of the photograph via four selector dials. Can be used with motor drive units at high shutter speeds and an electronic flash. imprint check light is also provided to ascertain at the moment of exposure. OFF setting also provided. Recordata Back 2 Section |
 |
250 Film Back 1: 250 Film Magazines Attached to the OM Body in place of the standard camera back, and used with the Motor Drive 1 or Winder 2 for roll films up to 250 exposures (10m or 32.7 ft long) minimizing frequent film loading and unloading. |
The 2 magazines are necessary; one holds the bulk film and a second is used as a film take-up. 250 Film back Section
 |
OM-Mount Endoscope Adapter Connects the OM bodies to the Olympus Fiberscopes for endoscopic photography. Focusing Screen 1-9 is specially prepared for endoscopic observation through the viewfinder. This adapter cannot be attached to the fiberscopes with distal end cameras. |
The Photomicro Group System Chart & Chart of Photographic Ranges
 |
Click to see |
 |
Click to download |
 |
How to use the Photomicro Adapters L & H ? |
Use
of Photomicro Adapter L For
photomicrography with the OM body, this adapter is used to mount a photo eyepiece
on the camera. The eyepieces available for this use are the NFK (FK), P and G. Each
of them requires a specific eyepiece adapter PM-ADF, PM-ADP or PM-ADG-3.
 |
For 20X objectives, with total magnification up to 250x, the Adapter L directly connects to either of these three eyepiece adapters. Note, however, that the Adapter L can be directly applied to the Olympus Universal Research Microscope VANOX, BH2 series microscopes and the Photomicrographic Stand PM-PSS for photomicrography with the OM body through the whole range of magnification. |
Use the Adapter L
 |
1. Replace the standard Focusing Screen 1-13 with the Screen 1-12. |
Picture magnification is determined by the following formula:
 |
 |
4. In photomicrography, microscopes require special eyepieces NFK, P or G for use With the OM body and Adapter L for low power magnification. |
 |
 |
NOTE: Only the objective has resolving power. The eyepiece serves merely to enlarge the image resolved by the objective. For a given total magnification involving different combinations of eyepieces and objectives, the use of a higher power objective will result in finer resolution. |
5. Select an eyepiece adapter suitable for the eyepiece in use.
Eyepiece Adapter PM-ADF for Photo Eyepieces NFK (or FK)
Eyepiece Adapter PM-ADR for Eyepieces P
Eyepiece Adapter PM-ADG-3 for Eyepieces G
NOTE: The VANOX (AH and BH series including AHB-LB, BH2) and PM-PSS DO NOT require any eyepiece adapter.
 |
6. Mount the Adapter L with camera onto the microscope. After selection of the Eyepiece/Eyepiece Adapter combination, mount the entire camera assembly on the microscope as follows: |
a. For Photo Eyepiece NFK (or FK)
1) Attach the Eyepiece Adapter PM-ADF to the photo tube of microscope, and clamp
with screw provided.
2) Insert the selected Eyepiece NFK (FK) into the Eyepiece Adapter PM-ADF, fit the
Adapter L over the Eyepiece Adapter PM-ADF pushing all the way down, and clamp the
entire camera assembly.
b. For Eyepiece P
4) Fit the Adapter L over the Eyepiece Adapter pushing all the way down and clamp the entire camera assembly.
C. For Eyepiece G10x
 |
1 ) Unscrew the upper part of the Eyepiece Adapter PM-ADG-3, insert the G10x into the lower part, and replace the upper part of the Adapter. |
d. For Eyepieces G15x and G20x
 |
1) Attach the Eyepiece Adapter PM-ADG-3 to the eyepiece sleeve, and clamp. |
e. For Eyepiece GWH 10x
 |
1) Use the intermediate ring marked with letters "GWH 10x", provided with the PM-ADG-3. |
5) Place the camera on the PM-ADG-3
and clamp.
6) Connect the entire assembly into one of the eyepiece sleeves of the stereo microscope,
and clamp.
 |
7. Adjust the camera position. If it is necessary to adjust the camera position, loosen the clamping screw provided on the Adapter L, rotate the camera to the desired position, and reclamp. |
1) Focusing with the OM System Focusing
Screen 1-12.
 |
Use the Dioptric Correction Lens or the Varimagni Finder, so that the double cross hairs within the field of view can be clearly recognized as two lines; otherwise correct focus cannot be obtained. |
9. Determine the exposure.
 |
1) In manual operation: Rotate the shutter speed ring or adjust light intensity by means of voltage adjustment of the light source or ND filters, until the needle in the viewfinder comes to the center of index marks. |
built in the OM-2.
If the subject is darker than the background,
turn the exposure ring or exposure compensation ring to overexpose by one or two
F stops according to the situation. On the contrary, if the subject is brighter than
the background, turn the ring to under-expose.
 |
[Use of Photomicrographic Stand PM-PSS) To set up the microscope on the PM-PSS, as illustrated above, please read the instructions provided with the stand, and then proceed as follows: 1. Set the Focusing Screen 1-12 to the OM body. 2. Place the microscope on the base of the PMPSS, so that the photo tube comes directly under the camera supporting arm. |
 |
a) For Photo Eyepiece NFK (FK) Put the light shield tube on the microscope photo tube, into which the selected Photo Eyepiece NFK (FK) is inserted slowly. b) For Eyepiece P Insert the selected Eyepiece P into the photo tube without the light shield tube. |
4. Looking through the camera mounting hole in the arm, let down the arm until the Eyepiece enters the hole (if necessary, adjust the microscope position so as to accurately center the Eyepiece in the hole).
 |
 |
5. Loosening the clamping screw provided on the Adapter L, put the Adapter L over the camera mounting hole, and clamp. |
6. Lower the arm slowly until it stops
(at this height, the diaphragm inside the Adapter L touches the top of the eyepiece).
Then raise the arm by about 1mm so that the Adapter L floats off to the Eyepiece.
Take care not to allow the periphery of the Eyepiece or light shield tube to come
into contact with the edge of the camera mounting hole. Then raise the collar to
support the arm.
7. Mount the OM body on the Adapter L.
8. Focus and expose.
|
|
 |
The Adapter H is a convenient unit for high magnification photornicrography with the Automatic Exposure Body PM-PBS or Manual Exposure Body PM-PBM. The Adapter H is used with the PM-D35S. |
Use the Adapter H
 |
1. Set the Focusing Screen 1-12 to the OM body. 2. Mount the Photomicro Adapter H on the OM body in the same manner as a normal interchangeable lens. 3. Attach the 35mm SLR Camera Adapter PMD35S to Automatic Exposure Body PM-PBS or Manual Exposure Body PM-PBM. |
 |
NOTE: To install the PM-D35S, align its locating pin with the locating groove on the automatic or manual exposure body and tighten the clamping ring. Insert the Photomicro Adapter H plus OM body into the PM-D35S, and clamp with locking knob. |
 |
4. Determine the magnification. Picture magnification is determined by the above formula. 5. Olympus microscopes- require Eye pieces NFK (FK), P or G for use with the OM body and Adapter H for high power magnification. 6. Select an Eyepiece Adapter appropriate to the Eyepiece in use. |
 |
 |
7. Mount the Adapter H with camera body onto the microscope. 8. Adjust the camera position; |
 |
9. Focus and exposure. For easier and more accurate focusing, it is recommended to use the PM-PBS or PM-PBM, Their uses are explained in detail in their instruction manuals. |
 |
|
| Previous | Back to Main Index Page of OM1(n) & OM2(n)
| Message Board | for
your favourite Olympus
OM-1(n)
and OM-2(n)
series models
| Message
Board | for your Zuiko
Optics in a shared environment
| Message Board | Specifically for Dispose or Looking for OM Photographic
Equipment
About this photographic site.
Home - Photography in Malaysia |
Copyright
© 2000.
leofoo ®. MIR Web Development Team.
Credit: My old time buddy,
Ahmad
Ikram,
Dr of Rubber Research Institute (RRI), Malaysia
who has loaned me his copy of the manual to prepare this section of the OM site;
Mr Poon of Foto Poon, Ipoh, Mr Richard, Ampang Park, Mr Lim
and Miss Jenny of Foto Edar for their generosity for their OM1(n), OM2n camera
and some Zuiko lenses. Mr Hans van Veluwen for mistakenly using
some content earlier from his OM website; J Sorensen
for providing some useful images to rectify some technical "flaws"; Mr
Gen Holst for helping during the early stages of development of this OM site;
Mr KKLow for some of his earlier images on the OM-1appeared in this website;
Miss Wati and Mirza for helping me
to convert this Operation Manual into a HTML format. Mr MCLau for rectifying
some mistakes made on the earlier preview sites. Site created 'unfortunately' again
with a PowerMac. A personal tribute to the
creator of the OM system and also a site dedicated to all the fans of Olympuses and
Zuiko Optics worldwide. Some of the content
and images appeared in this site were scanned from OM official marketing leaflets,
brochures and instruction manual(s) for educational purposes. Olympus is a registered
tradename of Olympus Optical Inc., Japan.

